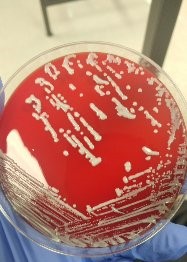
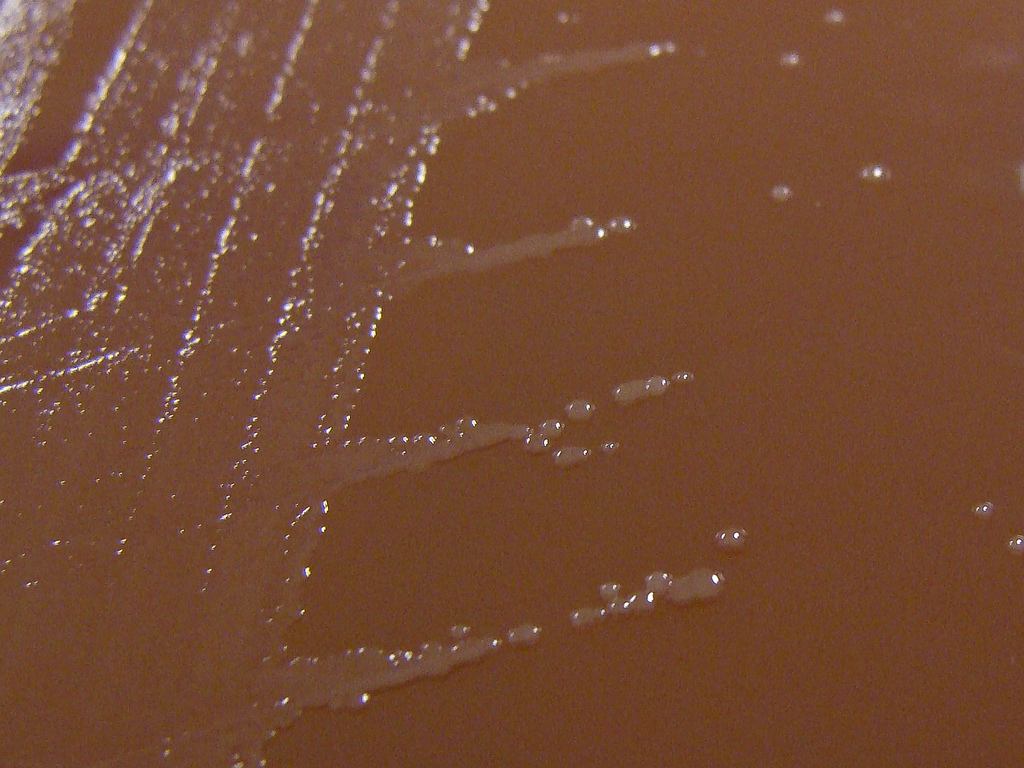
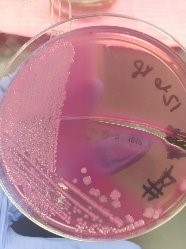
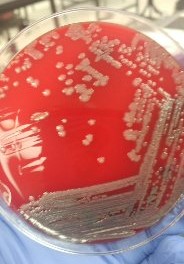
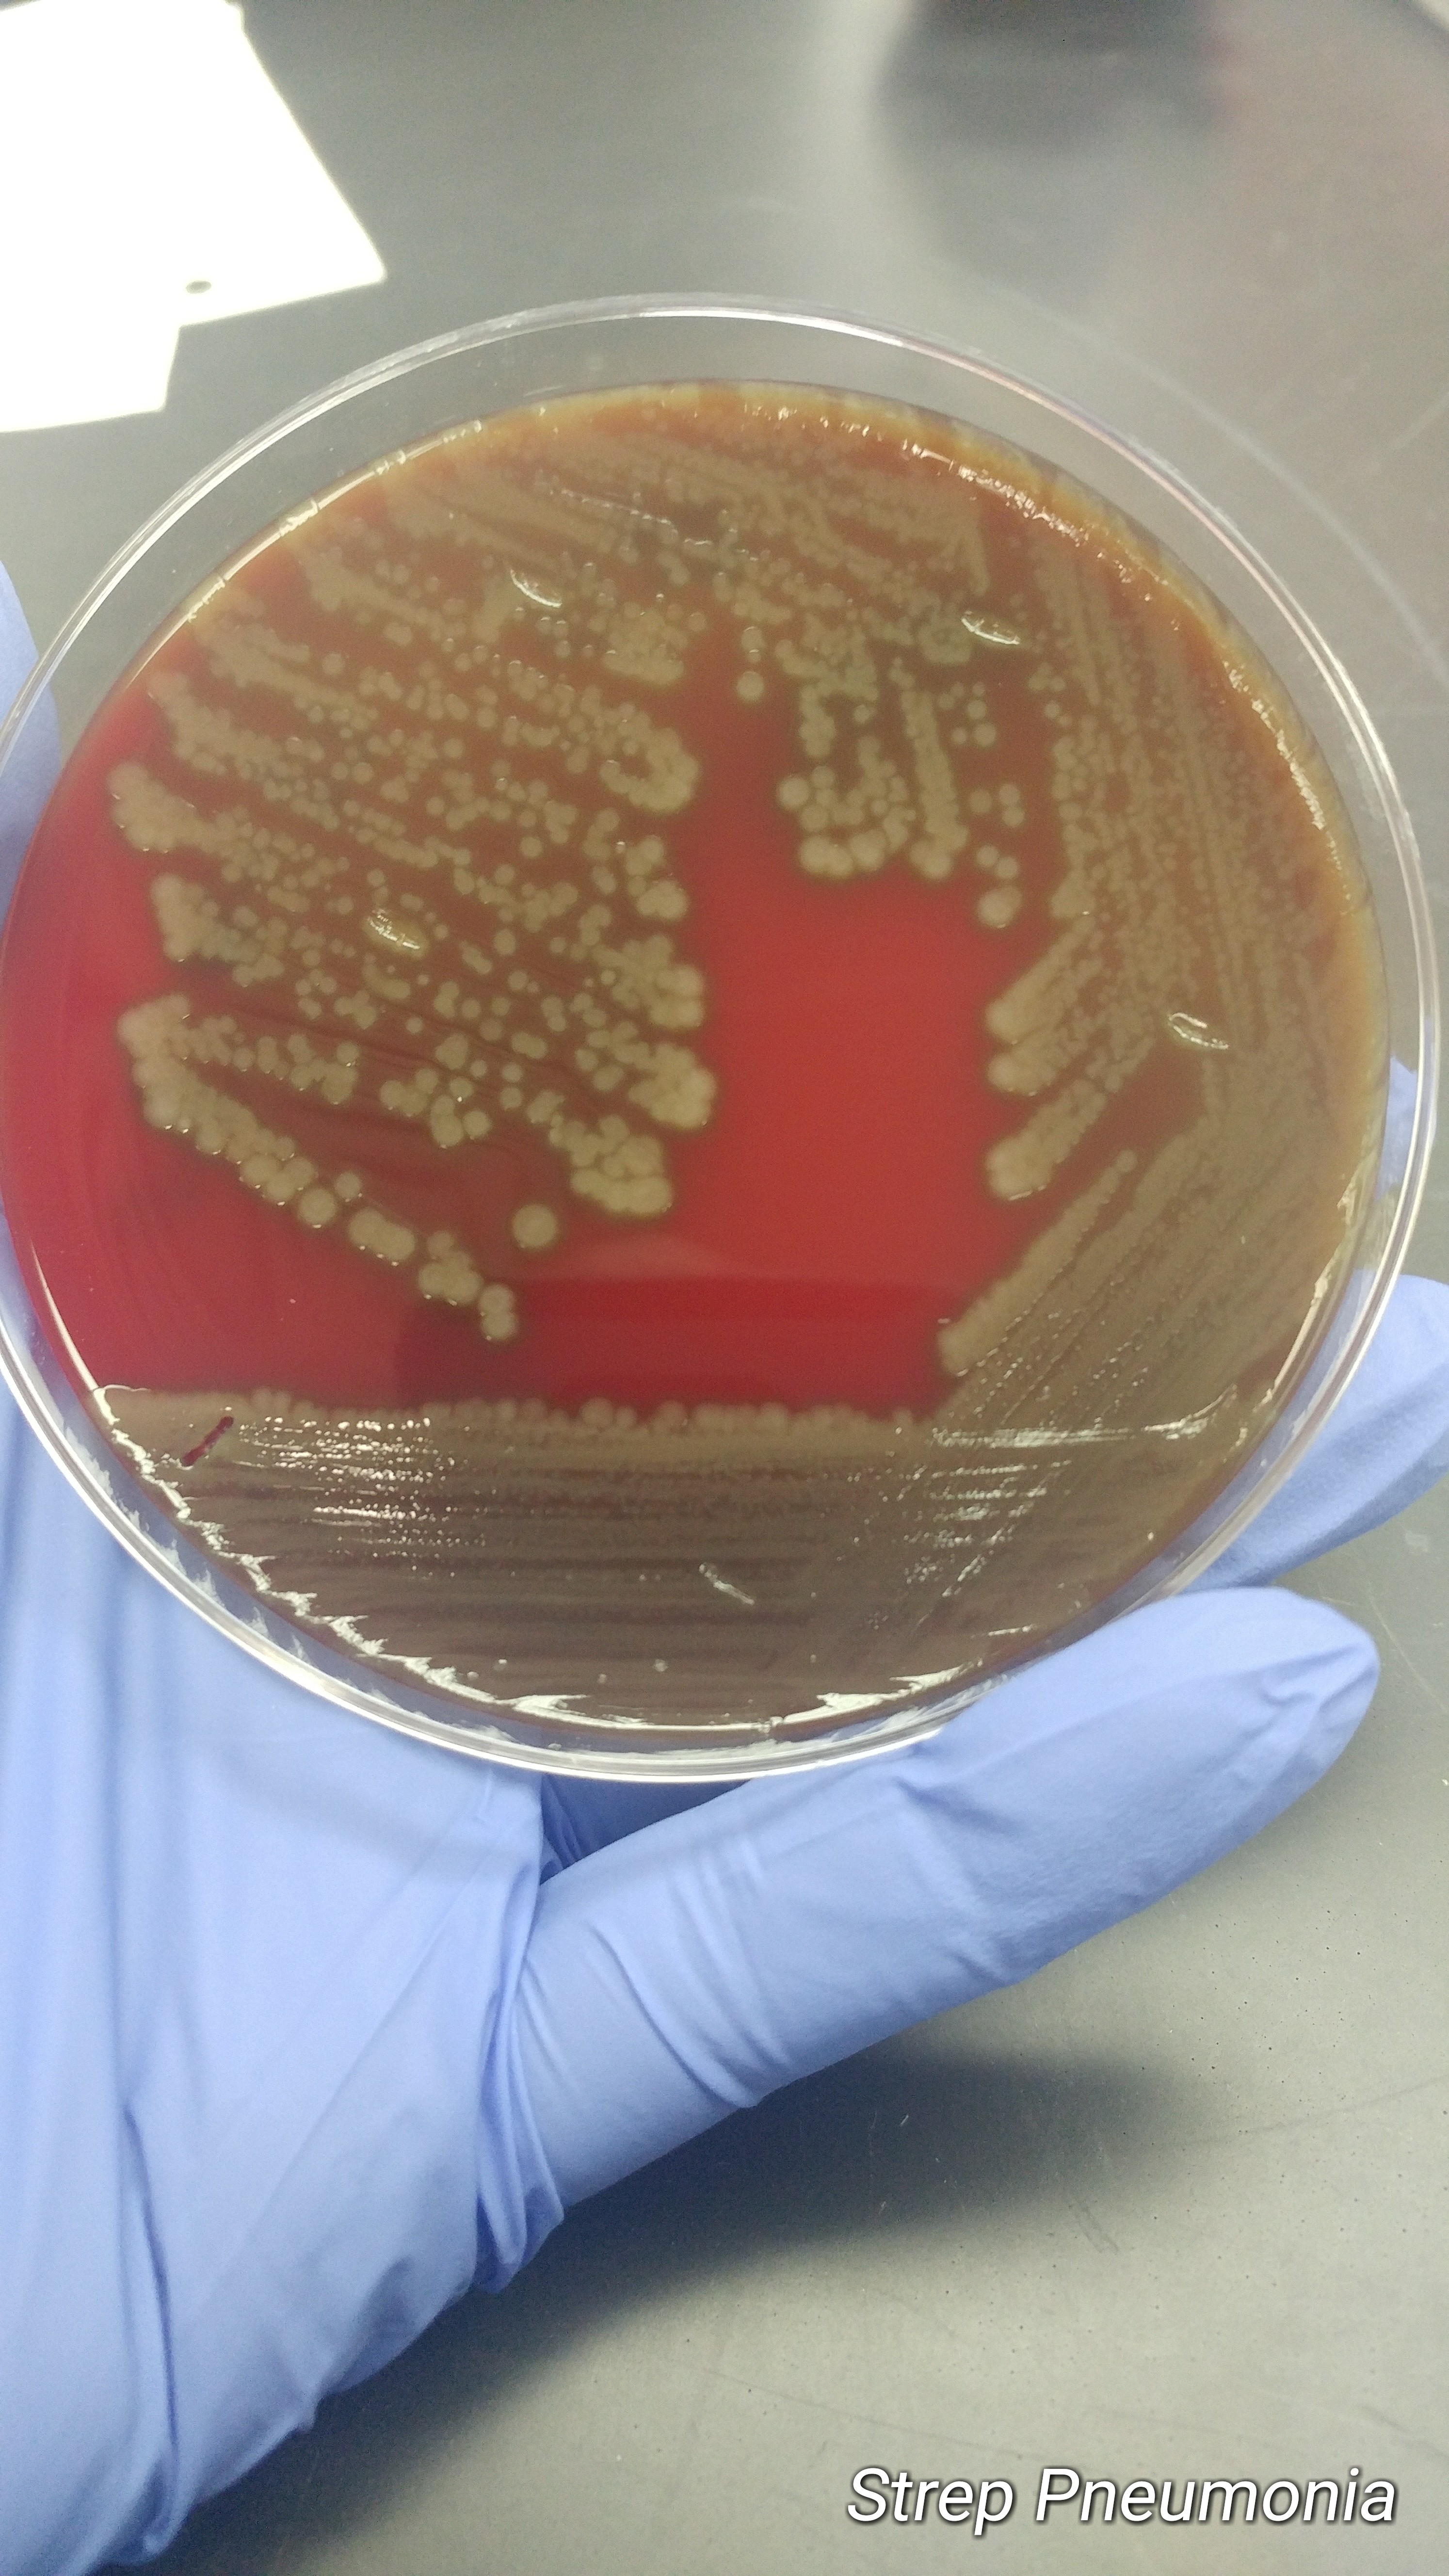
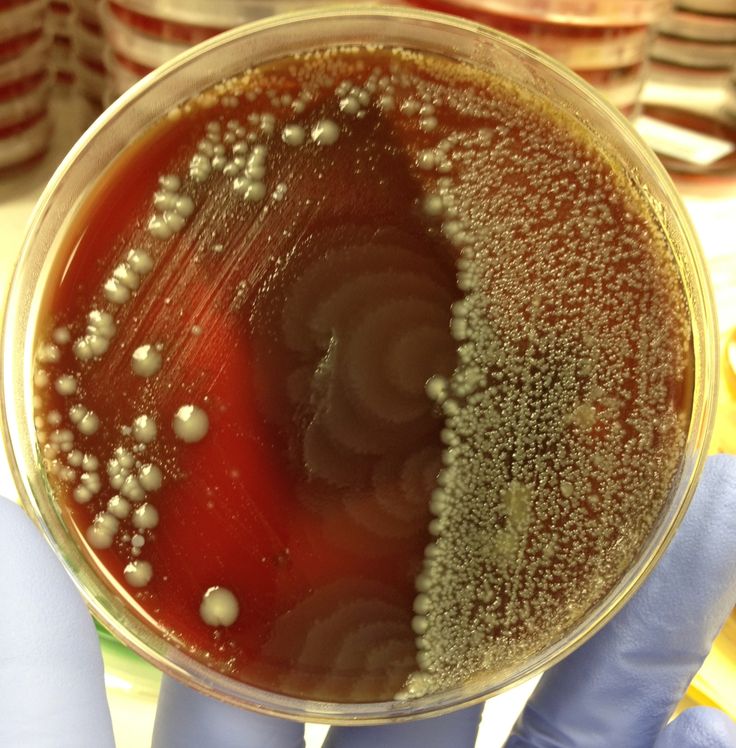
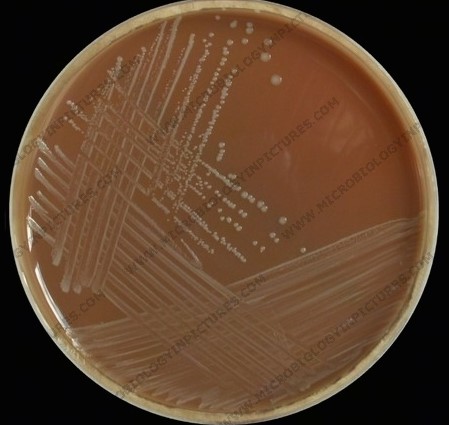
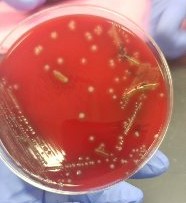
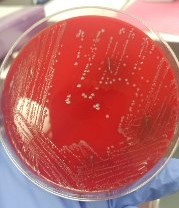
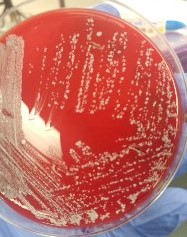

|
Java Games: Flashcards, matching, concentration, and word search. |
 |
 |
| A | B |
|---|
gram positive cocci in clusters, | Staphylococcus saprophyticus |
gram positive cocci in clusters, .jpg) | Staphylococcus aureus |
gram negative diplococci, | Neisseria gonorrhoeae |
gram negative bacilli, | E. coli |
gram negative bacilli, | Psuedomonas aeruginosa |
gram positive, lancet shaped diplococci, | Streptococcus pneumoniae |
gram positive cocci in chains,  | Streptococcus pyogenes |
gram negative bacilli, | Proteus mirabilis |
gram negative coccobacilli, | Haemophilus influenzae |
gram positive cocci in chains, | Streptococcus agalactiae |
gram positive cocci in chains, | Enterococcus faecalis |
gram positive cocci in clusters, | Staphylococcus epidermidis |
gram negative bacilli,  | Klebsiella pneumoniae |
|
| |